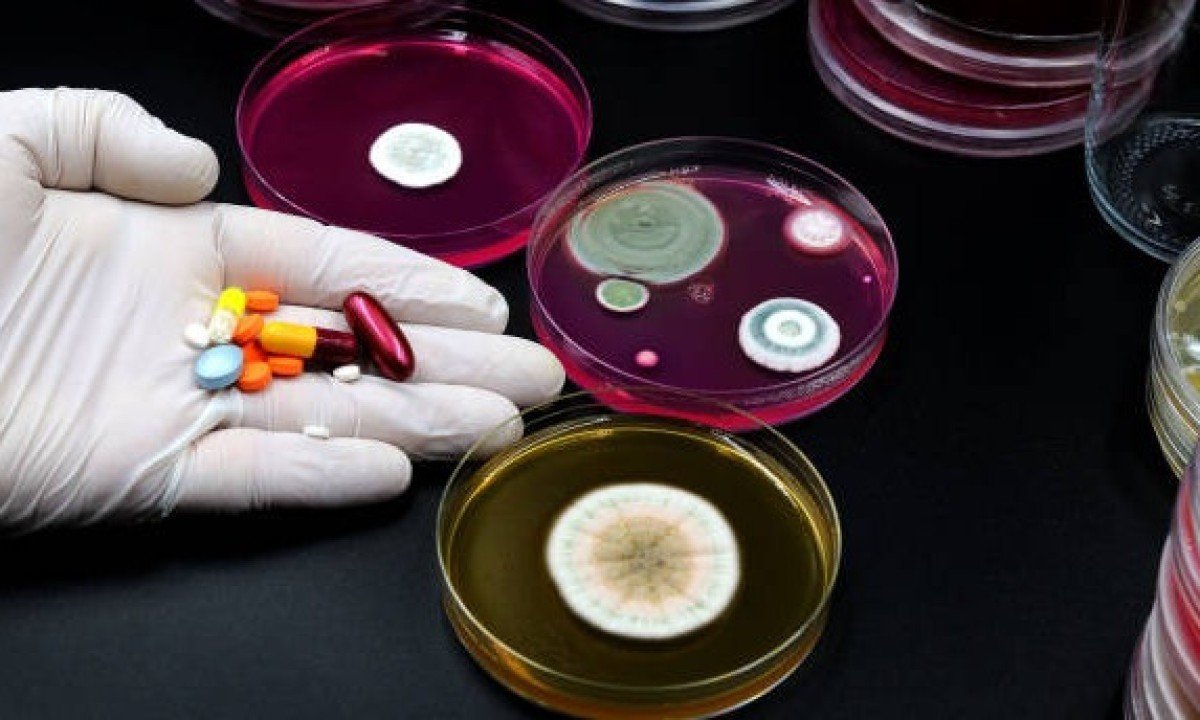

Superbactérias: como o uso incorreto de antibióticos ameaça sua saúde
O alerta da OMS é sério: a resistência bacteriana pode tornar doenças comuns intratáveis; entenda o risco e saiba como usar os medicamentos com segurança
compartilhe
SIGA
A Organização Mundial da Saúde (OMS) emitiu um alerta global sobre o avanço silencioso da resistência aos antibióticos, uma ameaça que pode transformar infecções comuns em doenças fatais. O uso incorreto e excessivo desses medicamentos está criando “superbactérias” capazes de resistir aos tratamentos, colocando em risco procedimentos médicos de rotina e a saúde de milhões de pessoas.
O problema surge quando as bactérias se adaptam e sobrevivem aos fármacos projetados para eliminá-las. Segundo o Relatório Glass 2025 da OMS, uma em cada seis infecções bacterianas no mundo já demonstra resistência a antibióticos. Isso acontece principalmente pelo uso indevido de medicamentos, como interromper o tratamento antes do prazo, usar doses incorretas ou tomar o remédio sem prescrição para tratar infecções virais, como gripes e resfriados, contra as quais eles não têm efeito.
Leia Mais
Quando um tratamento é interrompido, as bactérias mais fracas morrem, mas as mais resistentes sobrevivem. Elas então se multiplicam e transferem essa capacidade de resistência para outras bactérias, gerando linhagens cada vez mais difíceis de combater. Esse cenário compromete a eficácia de tratamentos para pneumonia, tuberculose e infecções hospitalares.
O que são as superbactérias?
Não se trata de um novo tipo de micróbio, mas sim de versões de bactérias comuns, como Acinetobacter baumannii e Klebsiella pneumoniae, que desenvolveram defesas contra os antibióticos. Cirurgias, transplantes de órgãos e tratamentos de quimioterapia, que dependem desses fármacos para prevenir infecções, podem se tornar procedimentos de altíssimo risco.
Estudos projetam que, sem ações urgentes, as mortes por infecções resistentes podem chegar a 10 milhões de pessoas anualmente até 2050, um cenário que exige resposta global coordenada. O relatório reforça a necessidade de um esforço conjunto entre governos, profissionais de saúde e a população para preservar a eficácia desses medicamentos essenciais.
Como usar antibióticos de forma segura
A responsabilidade de combater a resistência bacteriana é compartilhada. Adotar práticas seguras no uso de medicamentos é fundamental para proteger a sua saúde e a da comunidade. A principal recomendação é nunca tomar antibióticos por conta própria.
Confira outras medidas essenciais:
-
Siga a receita médica à risca: use a dose recomendada nos horários corretos. Alterar a dosagem pode comprometer a eficácia do tratamento.
-
Complete o tratamento: mesmo que os sintomas desapareçam, é crucial tomar o medicamento por todo o período prescrito pelo médico para garantir a eliminação total das bactérias.
-
Não se automedique: nunca use sobras de antibióticos de tratamentos anteriores ou aceite a indicação de outras pessoas. Apenas um profissional de saúde pode diagnosticar a necessidade do remédio.
-
Evite pressionar por uma prescrição: confie no diagnóstico médico. Se um antibiótico não for receitado, é porque provavelmente não é necessário para o seu quadro clínico.
Siga nosso canal no WhatsApp e receba notícias relevantes para o seu dia
Uma ferramenta de IA foi usada para auxiliar na produção desta reportagem, sob supervisão editorial humana.
